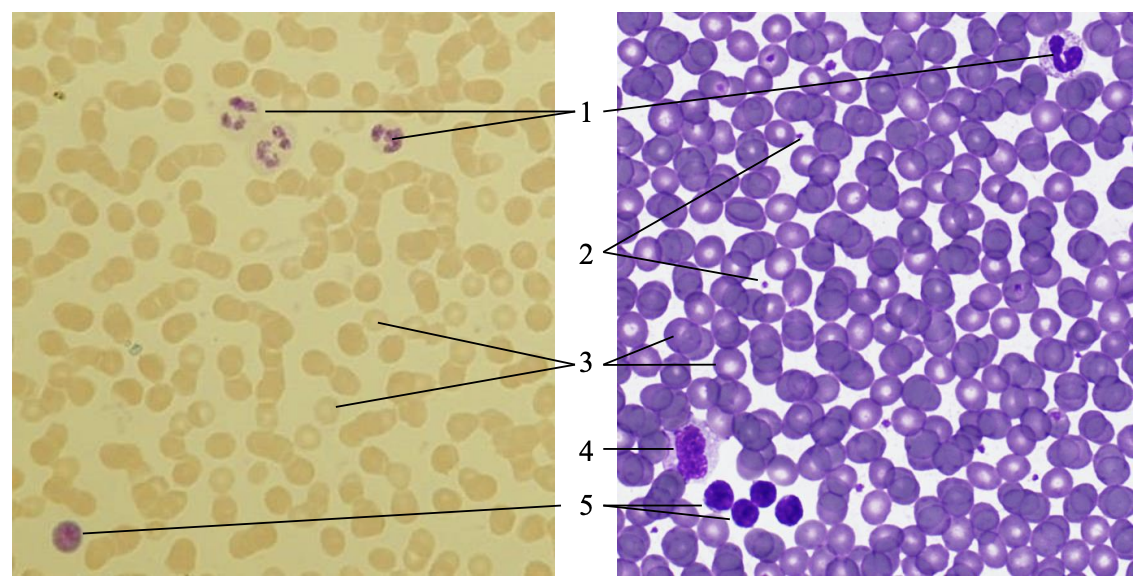
knowt flashcard image

nervai raumenys kaulai
1/46
There's no tags or description
Looks like no tags are added yet.
Name | Mastery | Learn | Test | Matching | Spaced | Call with Kai |
|---|
No study sessions yet.
47 Terms
daugiapolis neuronas (1 - neurono kūnas; 2 – branduolys; 3 – atauga; 4 – branduolėlis; 5 – nervinė skaidula; 6 – gliocito branduolys)

ruožuotasis griaučių miocitas (1 - išilginis pjūvis; 2 - skersinis pjūvis; 3 - įstrižinis pjūvis; 4 – branduolys; 5 – purusis kolageninis jungiamasis audinys)

sferiškoji ląstelė (1 - neutrofilinis granulocitas; 2 - kraujo plokštelė; 3 - eritrocitas; 4 - monocitas; 5 - limfocitas)
riebalų intarpai (1 - hepatocitas; 2 – hepatocito branduolys; 3 – riebalų intarpai)

Goldžio kompleksas (1 – mazgo gliocitas; 2 – neurono branduolys; 3 – neurono branduolėlis; 4 – Goldžio kompleksas)

pigmento melanino granulės (1 - daugiapolis neuronas; 2 – melanino granulės; 3 – gliocito branduolys; 4 – nervinės skaidulos; 5 – neurono branduolys; 6 – neurono branduolėlis)

vienasluoksnis plokščiasis epitelis (mezotelis) (1 – branduolys; 2 – plazmolema; 3 - citoplazma)

tariamai daugiasluoksnis epitelis (1 - blakstienėlės; 2 - paviršinis (stulpinis) epiteliocitas; 3 - taurinis egzokrinocitas; 4 - įterptinis epiteliocitas; 5 - pamatinis epiteliocitas; 6 - pamatinė membrana; 7 - poepitelinis jungiamasis audinys)

daugiasluoksnis plokščiasis neragėjantis epitelis (1 - poepitelinis jungiamasis audinys; 2 - pamatinė membrana; 3 - pamatinis sluoksnis; 4 - tarpinis sluoksnis; 5 - paviršinis sluoksnis)

daugiasluoksnis plokščiasis ragėjantis epitelis (I – epidermis; II – tikroji oda (derma) 1 – pamatinis sluoksnis; 2 – dygliuotasis sluoksnis; 3 – grūdėtasis sluoksnis; 4 - skaidrusis sluoksnis; 5 – raginis sluoksnis)

daugiasluoksnis pereinamasis epitelis (1 - poepitelinis jungiamasis audinys; 2 - pamatinis sluoksnis; 3 - tarpinis sluoksnis; 4 - paviršinis sluoksnis)

vienaląstė liauka (taurinis egzokrinocitas) (1 - žarnos epitelis; 2 - poepitelinis jungiamasis audinys; 3 - žarnos kripta; 4 - vienaląstė liauka (taurinė ląstelė); 5 - pamatinė membrana)

purusis kolageninis jungiamasis audinys (1 - elastinė skaidula; 2 - kolageninė skaidula)

glaudusis taisyklingasis kolageninis jungiamasis audinys (1 – kolageninių skaidulų pluoštas; 2 – fibroblastocito branduolys; 3 – purusis kolageninis jungiamasis audinys)

elastinis jungiamasis audinys (1 – purusis kolageninis jungiamasis audinys; 2 – kolageninės skaidulos; 3 – elastinės skaidulos; 4 – fibrocitų ir fibroblastocitų branduoliai)

makrofagocitai, fagocitavę anglies dulkes (1 – fagocituotos anglies dulkės; 2 – makrofagocito branduolys)

riebalinis jungiamasis audinys (1 – glaudusis netaisyklingas kolageninis jungiamasis audinys; 2 - adipocito branduolys; 3 – griaučių ruožuotasis miocitas)

retikulinis (tinklinis) jungiamasis audinys (1 – glaudusis netaisyklingas kolageninis jungiamasis audinys; 2 - limfocito branduolys; 3 – retikulocitas; 4 – pagrindinė medžiaga)

puriojo kolageninio jungiamojo audinio sandaros schema

purusis kolageninis jungiamasis audinys (A – fibrocitas; B – fibroblastocitas; C – adipocitai; D – putliosios ląstelės; E – plazmocitas; F, G - makrofagocitai)

hialininė kremzlė (I – antkremzlis; II - kremzlė 1 – fibrocitas; 2 - skaidulinis sluoksnis; 3 - chondrogeninis sluoksnis; 4 – chondroblastocitas; 5 - tarpląstelinė medžiaga; 6 - izogeninė chondrocitų grupė)

elastinė kremzlė (I – antkremzlis; II - kremzlė 1 – fibrocitas; 2 - skaidulinis sluoksnis; 3 - chondrogeninis sluoksnis; 4 – chondroblastocitas; 5 - tarpląstelinė medžiaga; 6 - izogeninė chondrocitų grupė; 7 - elastinė skaidula)

skaidulinė kremzlė (I – besiformuojančios slankstelio kaulinės sijos; II - hialininė kremzlė; III – skaidulinė kremzlė 1 – chondrocitas; 2 - kolageninės skaidulos)

kaulinis audinys (1 – išorinis antkaulis; 2 – išorinės žiedinės kaulinės plokštelės; 3 – osteonas (Haverso sistema); 4 - plokštelinis kaulinis audinys; 5 – intersticinė (įterptinė) kaulinė plokštelė; 6 – vidinės žiedinės kaulinės plokštelės)

kaulo formavimasis iš mezenchimos (1 - burnos epitelis; 2 - danties užuomazga; 3 - kaulinio audinio sijos; 4 - hialininė kremzlė; 5 - oda su plaukų folilulų užuomazgomis)

kaulo formavimasis iš hialininės kremzlės (kremzlinė osteogenezė) (1 - oda; 2 – besiformuojantis pirštakaulis)

kaulinis audinys (1 – osteonas (Haverso sistema); 2 – osteocito kūnas; 3 - koncentriška kaulinė plokštelė; 4 - Haverso kanalas; 5 - cementinė linija; 6 – intersticinė (įterptinė) kaulinė plokštelė)

kaulo formavimas iš mezenchimos (membraninė osteogenezė) (1 - osteoblastocitas; 2 - osteocitas; 3 - osteoidas; 4 - ektomezenchima; 5 – osteoklastocitas; 6 - kraujagyslė)

kaulo formavimasis iš hialininės kremzlės (kremzlinė osteogenezė) (I – antrinis kaulėjimo centras; II – pirminis kaulėjimo centras 1 - antkremzlis; 2 – epifizinė plokštelė; 3 – antkaulis; 4 – periostinis kaulinis audinys; 5 – besiformuojantys kaulų čiulpai)

kaulo formavimasis iš hialininės kremzlės (epifizinė plokštelė) (1 - atsarginė zona; 2 - vešėjimo zona; 3 - hipertrofijos zona; 4 - rezorbcijos zona; 5 - kaulėjimo zona)

griaučių ruožuotasis raumeninis audinys (1 – miocitų įstrižinis pjūvis; 2 miocitų išilginis pjūvis; 3 - miocitų skersinis pjūvis; 4 – kraujagyslė; 5 – perimiziumas; 6 - endomiziumas)

širdies ruožuotasis raumeninis audinys (išilginis pjūvis) (1 – įterptinis diskas; 2 – endomiziumas; 3 – kardiomiocito branduolys)

neruožuotasis raumeninis audinys, išilginis pjūvis (1 – neruožuotojo miocito branduolys; 2 – endomiziumas; 3 - perimiziumas)

griaučių ruožuotieji miocitai (I – išilginis pjūvis; II - skersinis pjūvis 1 – ruoželiai (A ir I diskai); 2 – miocito branduolys; 3 – endomiziumas; 4 - perimiziumas)

storosios žarnos sienelės pjūvis (I – gleivinė; II – pogleivinė; III – raumeninis dangalas; IV – seroza 1 – vidinis žiedinis neruožuotųjų miocitų sluoksnis; 2 – išorinis išilginis neruožuotųjų miocitų sluoksnis)

neruožuotasis raumeninis audinys, skersinis pjūvis (1 – neruožuotojo miocito branduolys; 2 – perimiziumas)

neuronai (chromatofilinė medžiaga - Nislio kūneliai) (1 – neurono kūnas; 2 – branduolys; 3 – branduolėlis; 4 – chromatofilinė medžiaga; 5 –gliocito branduolys)

ependimocitai (1 - pilkoji medžiaga; 2 – ependimocitas; 3 – centrinis kanalas; 4 – gliocito branduolys; 5 – nervinė skaidula)

periferinė mielininė nervinė skaidula (1 – ašinis cilindras; 2 – neurolemocito branduolys; 3 – mielininis dangalas; 4 – Ranvje mazgas)

Meisnerio kūnelis (1 – epidermis; 2 – Meisnerio kūnelis; 3 – tikrosios odos (dermos) spenelinis sluoksnis; 4 – galinio gliocito branduolys; 5 - aferentinė nervinė skaidula)

Pacini kūnelis (1 – kapsulė; 2 – kraujo kapiliaras; 3 – jungiamojo audinio plokštelė; 4 – fibrocitas; 5 -aferentinė nervinė skaidula; 6 – vidinis stormuo)

nervinės galūnelės (neplaukuota oda) (1 – epidermis; 2 – tikroji oda (derma); 3 – poodis (hipoderma))

hematoksilinas-eozinas (citoplazma dažosi rožine spalva, branduolys ir citoplazmoje esanti RNR – tamsiai mėlyna)
koks čia dažymo būdas?

sudanas III arba osmio rūgštis
koks čia dažymo būdas?

gimzos ir romanovskio dažai
koks čia dažymo būdas?

impregnavimas sidabru
koks čia dažymo būdas?

metileno mėlis
koks čia dažymo būdas?
